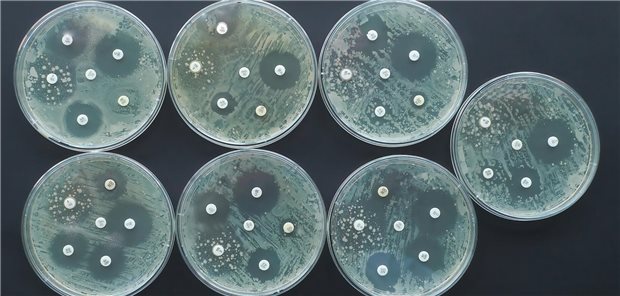
Antibiotikaresistenzen: Fast 10.000 Todesfälle in Deutschland im Jahr 2019 Test auf Antibiotikaresistenzen

Themenseite Sepsis
Themenseite - Sepsis
Versorgungsloch nach Klinikentlassung
Langzeitfolgen nach Sepsis: Tipps für die Diagnose des Post-Intensive-Care-Syndroms
13.09.2025
|
Versorgungsloch nach Klinikentlassung
Langzeitfolgen nach Sepsis: Tipps für die Diagnose des Post-Intensive-Care-Syndroms
20.08.2025
|
Geschätzte Werte
Antibiotikaresistenzen: Fast 10.000 Todesfälle in Deutschland im Jahr 2019
20.08.2025
|
Fehlregulation des Immunsystems
Kinder mit Sepsis: EBV-Seropositivität mit Sterblichkeit assoziiert
Podcasts
„ÄrzteTag“-Podcast
Sepsis – was sind die neuen Empfehlungen zu Diagnose und Nachsorge, Professor Brunkhorst?
„ÄrzteTag“-Podcast
Sepsis früh erkennen – achten Sie auf diese Red Flags!
Meinung